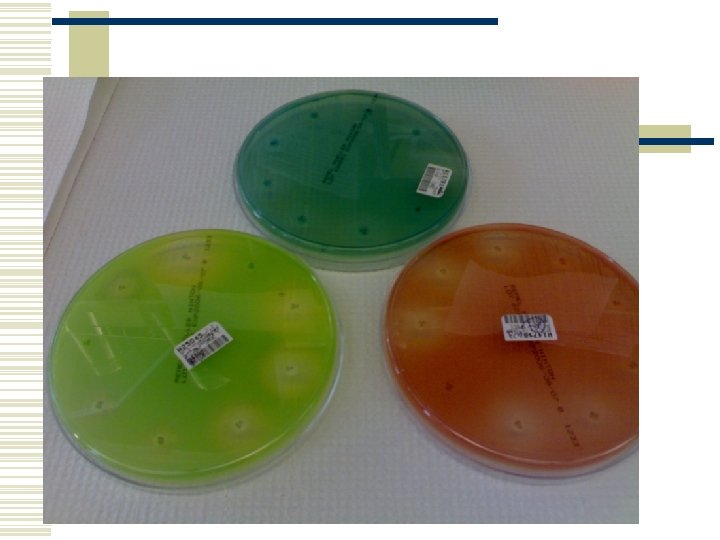

PSEUDOMONAS ENFEKSYONLARI Do Dr Arzu FINDIK OM Veteriner

- Slides: 57
PSEUDOMONAS ENFEKSİYONLARI Doç. Dr. Arzu FINDIK OMÜ Veteriner Fakültesi Mikrobiyoloji Anabilim Dalı
TANIM İnsan ve çeşitli hayvanlarda, Pseudomonas cinsi içerisindeki mikroorganizmalar tarafından oluşturulan enfeksiyonlardır.
Pseudomonas cinsinin Taksonomik yeri w Alem (Kingdom): Bacteria w Filum (Phylum): Proteobacteria w Sınıf (Class): Gamaproteobacteria w Takım (Order): Pseudomonadales w Alt takım (Suborder): Pseudomonadineae w Aile (Familya): Pseudomonadaceae
Taksonomik yeri w Cins (Genus): n Pseudomonas Azomonas n Azotobacter n Cellvibrio n
Pseudomonadlar w Pseudomonas cinsindeki bakterilere benzer ekofizyolojik özelliklere sahip olan bakterileri ifade eder. Önceden Pseudomonas cinsi içinde olan bu bakteriler, filogenetik uzaklıklarından dolayı alpha Proteobacteria arasında diğer cins, familya veya takımlara geçmişlerdir. n n Xanthomonas Zoogloea
Klasifikasyon w Ribozomal RNA homolojilerine göre, beş doğal takımdan biri içerisinde klasifiye edilirler. “RNA benzerlik grupları” (Tablo 1). Yaklaşık 40 tür bulunur (floresans pseudomonaslar arasındaki biovarlar ve fitopatojenik serovarlar hariç).
Tablo 1 RNA benzerlik grubu Grubu oluşturan türler I P. aeruginosa, P. fluorescens (çeşitli biovarlar), P. putida, P. chlororaphis, P. syringae (birçok patovar), P. cichorii, P. stutzeri, P. mendocina, P. alcaligenes, P. pseudoalcaligenes, P. agarici, P. angulata, P. fragi, P. synxantha, P. taetrolens, P. mucidolens, P. oleovorans, P. Resinovorans II P. cepacia, P. gladioli, P. caryophylli, P. pseudomallei, P. solanacearum, P. pickettii, P. pyrrocinia, P. andropogonis III P. (Comamonas) acidovorans, P. (Comamonas) testosteroni, P. saccharophila, P. facilis, P. delafieldii, P. alboprecipitans, P. Palleronii IV P. diminuta, P. Vesicularis V Xanthomonas spp. , X. (Pseudomonas) maltophilia, P. geniculata, P. Gardneri
İsim değişiklikleri Pseudomonas mallei Burkholderia mallei Pseudomonas pseudomallei Burkholderia pseudomallei Pseudomonas (Xanthomonas)maltophila Stenotrophomonas maltophila
Grup I w En büyük grup w Floresans türler (P. aeruginosa, P. fluorescens gibi)ve bitki patojenlerini (P. syringae ve P. cichorii gibi) içerir. Ayrıca çeşitli önemli floresans olmayan türleri (P. stutzeri ve P. mendocina)içerir. w P. aeruginosa, insan ve hayvanların pseudomonas türleri içindeki en önemli opurtinistik patojenidir. Cins içindeki en önemli veteriner patojendir. w P. aeruginosa’nın tersine, P. fluorescens heterojen türler olup biyotipler veya biovarlara ayrılır. Gıdalarda bozulmaya neden olur, sürüngen ve balıklarda lezyonlara neden olur.
Grup II Esas olarak patojenlerden oluşur. Pseudomonas (Burkholderia) cepacia, grubun en önemli üyelerinden olup bitki ve insan patojenidir. Pseudomonas (Burkholderia) pseudomallei ve Pseudomonas (Burkholderia) mallei, sırasıyla melioidozis ve ruamın etkenleridir.
Grup III w 5 tür tarafından temsil edilir. P. (Comamonas) acidovorans ve P. (Comamonas) testosteroni, diğer Pseudomonas türlerinden çok farklı bulunmuş ve yeni bir cins “Comamonas” içerisine sokulmuştur.
Grup IV w 2 cins bulunur. P. diminuta ve P. vesicularis
Grup V w Xanthomonas ve Stenotrophomonas türlerini içerir. Stenotrophomonas maltophilia bir çok doğal habitatta saprofit olarak bulunur ve ayrıca bazen klinik örneklerden izole edilir.
Doğal Habitat w Çoğu saprofittir. Çevresel mikroorganizmalar olup tipik olarak suda, toprakta, bitkilerin üzerinde, meyve ve sebzelerde bulunurlar. w Sulu ortamları tercih ederler ve buralarda canlılıklarını uzun süre devam ettirirler. Hastane ortamları için problemdir. Dezenfektanlar, merhemler, sabun, göz damlaları, irrigasyon sıvıları ve ekipmanlar P. aeruginosa için potansiyel kaynaklardır. Havalandırma ve lavabo giderlerinde sıklıkla bulunur
Doğal Habitat w P. aeruginosa sağlıklı hayvanların mikrofloralarında (deri ve mukoz membranlar, özellikle gastrointestinal kanal)da bulunur w B. mallei, Malleus, OIE-World Organization for Animal Health tarafından listelenmiş Ruam (Malleus, Glanders)’ın etkeni
Doğal Habitat w B. pseudomallei; meliodiosis hastalığının etkeni olup özellikle tropik veya subtropik bölgelerde bulunur. Özellikle pirinç yetiştirilen (Tayland, Vietnam) yerlerde. w S. maltophila; su, toprak ve kanalizasyonlardan sıklıkla izole edilir. Hayvanlar ve immun sistemi baskılanmış insanlarda oppurtinistik bir patojen olarak görülmektedir.
Etiyoloji w Gram negatif, çomak w Zorunlu aerobik w Çoğu oksidaz ve katalaz (+) w Hareketli (bir veya daha fazla polar flagella) w Sporsuz w Kapsülsüz
P. aeruginosa Enfeksiyonları -Etiyolojiw Genel özellikleri taşır w Bazı suşları kapsüllüdür w Optimum 37°C’de üremekle birlikte 22 -42 °C’lerde de üreyebilir. w Çoğu beta hemoliz yapar w Koloniler büyük, düzgün, gri-mavi renkte ve “aminoacetophenone”’dan kaynaklanan tipik üzüm benzeri, meyvemsi bir kokuya sahiptir
P. aeruginosa Enfeksiyonları -Etiyolojiw Mavi renkli “pyocyanin” pigmenti sentezler w Klinik örneklerden genellikle S-tipli, büyük, nemli ve yaygın koloniler, çevreden ise R-tipli koloniler izole edilir. w Solunum ve üriner sistem akıntılarından izole edilen suşlar biyokimyasal olarak atipik olup M-tipli koloni oluşturur
P. aeruginosa Enfeksiyonları -Etiyolojiw Mac. Conkey Agar’da yeşilimsi-mavi, solgun koloniler (laktoz negatif) oluşur. Brillant green ve XLD (Xylose Lysine Deoxycholate) agarda kırmızı koloniler (alkali reaksiyon) oluşur. XLD agarda H 2 S oluşmaz.
P. aeruginosa Enfeksiyonları -Etiyolojiw Pyocyanin (mavi), pyoverdin (sarı), pyorubin (kırmızı) ve pyomelanin (koyu kahverengi) pigmentleri (eriyebilir) sentezler. w Pyorubin ve pyomelanin daha yavaş ve daha az sentezlenir. Nutrient agarda 2 hafta oda ısısında bekletilen kültürlerde en iyi görülür.
P. aeruginosa Enfeksiyonları -Etiyolojiw Pyocyanin P. aeruginosa’nın laboratuvar teşhisinde önemlidir. w Pseudomonas agar P, pyocyanini ve Pseudomonas agar F de pyoverdin üretimini destekleyen besi yerleridir
P. aeruginosa Enfeksiyonları -Etiyolojiw Pyocyanin, önceden “fluorecein” olarak bilinirdi. UV altında floresan verir. w CHO’ları fermente edemez. w TSI agarda gaz oluşturmadan alkali reaksiyon meydana getirir.
P. aeruginosa Enfeksiyonları -Etiyoloji. Hareket Katalaz Oksidaz Hemoliz 42 °C’de üreme 4 °C’de üreme İndol MR VP TSIA’da yüzey + + + Alkali Lizin dekarboksilaz Glukozdan asit (O-F) Laktozdan asit Jelatin hidrolizasyon Üreaz Nitrat Sitrat TSIA’da dip + + + alkali
P. aeruginosa Enfeksiyonları -Etiyolojiw Pyocin adı verilen bir bakteriyosin üretir ve aynı türün diğer suşları için öldürücüdür w Çok sayıda litik fajı vardır
P. aeruginosa Enfeksiyonları -Antijenik özellikw 17 adet somatik “O” (ısıya dirençli) ve 6 adet flagellar “H” antijeni (ısıya duyarlı)
P. aeruginosa Enfeksiyonları -Patogenezw Fosfataz, proteaz, fosfolipaz, ekzotoksin-A, ekzoenzim-S, alkalin proteaz ve elastaz, enterotoksin gibi bir çok ürün sentezler. n n Ekzotoksin-A; hücresel hasar, makrofajlar için toksik Ekzoenzim-S; yara ve yanık enfeksiyonlarında doku hasarı Proteazlar; deri ve iç organlarda hemorajik lezyonlar Elastaz; pnömoni olgularında akciğer hasarı
P. aeruginosa Enfeksiyonları -Patogenezn n n Fosfolipaz ve glikolipidler; pnömoni şekillenmesinde Slime faktörü; antifagositik olup penetrasyonu kolaylaştırır Ekzoenzim-S, Slime faktörü ve dış membran lipopolisakkaritlerinin antifagositik etkileri hep birlikte konak dokularında kolonizasyon ve replikasyon
P. aeruginosa Enfeksiyonları -Patogenezn n n Diğer virulens faktörleri arasında, komplemente dirençlilik ve konak dokularından demir elde etme yeteneği vardır. Ayrıca pilusları ve bazı suşlarda da kapsül (antifagositik) vardır Pyocin’ler ve pigmentler antimikrobiyel özellik gösterir
P. aeruginosa Enfeksiyonları -Patogenezn Doku zedelenmesi (yara, yanık, vb) malignite ve immun yetmezliğe bağlı direnç düşüklüğü, antibiyotik tedavisi sonrasında ortaya çıkan floradaki bakteri sayısındaki azalma predispozisyon faktörleridir.
P. aeruginosa Enfeksiyonları -Patogenezw Adezinleri, epitel hücreler üzerindeki spesifik galaktoz veya mannoz veya sialik asit reseptörlerine bağlanır. Respiratorik kanalın kolonizasyonu için fimbrial adherens gerekir ve bunda fibronektini degrade eden proteaz enziminin de yardımı olabilir. w Opurtinistik adherens, Pseudomonas keratitisi ve uriner ve respiratorik kanal enfeksiyonlarında önemli bir basamaktır.
P. aeruginosa Enfeksiyonları -Patogenezw Traheal epitel hücreler üzerindeki Pseudomonas pilusları için bulunan reseptörler sialik asit (N-acetylneuraminic acid) olabilir. Ekzopolisakkarit (alginate) üreten mukoid suşlar, traheobronşial müsine (Nacetylglucosamine) bağlanan ayrı ve alternatif bir adezine sahiplerdir. w Piluslar ve mukoid polisakkaritten başka iki hücre yüzey adezini daha vardır. w Ekzoenzim S, respiratorik hücreler üzerindeki glikolipidler için bir adezin olabilir.
P. aeruginosa Enfeksiyonları -Patogenezw İnvazyonda aktivite gösteren ekstrasellüler proteazlar: elastase ve alkaline protease’dır. n n n Elastaz ; kollajen, Ig. G, Ig. A ve komplementi parçalar, fibronektini lize eder, respiratorik epiteli dağıtır ve siliyer fonksiyonu önler. Alkalin proteaz; fibrin oluşumunu önler ve fibrini parçalar. Elastaz ve alkalin proteaz birlikte korneaya hasar verir, gamma Interferon (IFN) ve Tumor Nekrozis Faktörün (TNF) inaktivasyonuna neden olurlar.
P. aeruginosa Enfeksiyonları -Patogenezw İnvazyonda ayrıca 3 eriyebilir protein de görev yapar: sitotoksin ve iki hemolizin. n n Sitotoksin por oluşturan proteindir (lökosidin) Hemolizinlerden biri fosfolipaz, diğeri ise lesitinaz.
P. aeruginosa Enfeksiyonları -Patogenezw Pseudomonas pigmentlerinden pyocyanin, nazal silianın fonksiyonunu bozar, epiteli dağıtır. w Pyocyanin derivatı olan, pyochelin bir siderofordur.
P. aeruginosa Enfeksiyonları -Patogenezw Ekzotoksin A, difteri toksini ile aynı mekanizmaya sahiptir. Üretimi ekzojen demir tarafından regule edilir. Kolonizasyon bölgesinde nekrotize edici etki.
Epidemiyoloji w Su, toprak ve bitkiler üzerinde bulunur w Saprofitiktir w Sağlıklı hayvanların deri, mukoz membran ve dışkılarında bulunabilir w P. aeruginosa enfeksiyonları, genellikle yara, yanık, kornea zedelenmesi, derideki paraziter ve mikotik enfeksiyonlar, kulak yangıları, özellikle koyunlarda yapağının aşırı ıslanması, kötü hijyenik koşullar ve immun sistem zayıflığı gibi predispoze faktörler varlığında oluşur.
Epidemiyoloji w Mastitis olguları genellikle sağım sonrası meme loblarının kontamine su ile yıkanması veya kontamine meme içi antibiyotik tüplerinin kullanılması ile oluşur w Enfekte sperma ile kısrak ve ineklere bulaşma olabilir
Epidemiyoloji w Özellikle çok yağış alan bölgelerde (İngiltere, Avustralya, vb) aşırı yağmur ile yumuşayan deri üzerine yapağının yapışması, etkenin buraya kolonize olmasını kolaylaştırır ve suppuratif dermatitise öncülük eder. Etken tarafından sentezlenen pyocyanin pigmenti yapağıyı boyayabilir
Epidemiyoloji w Kontamine yemler ve solunum yoluyla bulaşma da söz konusu olabilir w Hastalık çoğu kez sporadik olmakla birlikte, minklerde ve çinçillalarda septisemik enfeksiyon formu epidemiler halinde görülebilir
P. aeruginosa’nın hayvan türlerinde oluşturduğu hastalık durumları Konakçı Hastalık Sığır Koyun Domuz At Köpek, kedi Mink Çinçilla Sürüngenler Papağan Mastitis, metritis, pnömoni, dermatitis, buzağılarda enteritis Mastitis, yapağı çürüğü, pnömoni, otitis media Solunum sistemi enfeksiyonları, otitis, enteritis Genital sistem enfeksiyonları, pnömoni, ülseratif keratitis Otitis eksterna, sistitis, pnömoni, ülseratif keratitis Hemorajik pnömoni, septisemi Pnömoni, septisemi Nekrotik stomatitis Ağır sistemik enfeksiyonlar, konjunktivitis, rinitis, hava kesesi yangısı, pnömoni, enteritis
P. aeruginosa Enfeksiyonları -Teşhisw Laboratuvar Teşhisi n n Marazi maddeler; irin, burun akıntısı, akciğer aspiratı, idrar, dışkı, süt, kulak svabı, uterus akıntısı, operasyon yaralarından alınan örnekler… Bakteriyoskopi; Gram negatif çomak
P. aeruginosa Enfeksiyonları -Teşhis. Kültür; KA ve Mac. Conkey Agar’a ekim. Ayrıca selektif besi yerlerinden (%0. 03 cetrimid içeren) yararlanılabilir. Pseudomonas Agar P ve F gibi ticari besi yerleri de kullanılabilir. Koloni tipi, tipik meyvemsi koku, hemoliz, metalik parlaklık yönünden değerlendirilir. Ayrıca Mac. Conkey’de yeşilimsi-mavi koloniler, Brillant green ve XLD agar’da kırmızı koloniler oluşturma özelliği değerlendirilir. API 20 E gibi ticari identifikasyon sistemleri n
P. aeruginosa Enfeksiyonları -Teşhis. Hareket Katalaz Oksidaz Hemoliz 42 °C’de üreme 4 °C’de üreme İndol MR VP TSIA’da yüzey + + + Alkali Lizin dekarboksilaz Glukozdan asit (O-F) Laktozdan asit Jelatin hidrolizasyon Üreaz Nitrat Sitrat TSIA’da dip + + + alkali
P. aeruginosa Enfeksiyonları -Teşhisn Hayvan deneyi; Tavşan, kobay, fare, vb deneme hayvanlarına deri altı düşük dozda etken inokule edilir, ateş ve lokal abselerin oluşumu gözlenir. Yüksek dozda damar içi verildiğinde septisemi ve ölüm şekillenir.
P. aeruginosa Enfeksiyonları -Teşhisn Serolojik testler; Aglutinasyon testi, ELISA, vb kullanılabilir
Sağaltım R faktörlerinden kaynaklanan çoklu antibiyotik direnci söz konusudur. Antibiyogram oldukça önem taşır. Dış membran LPS’i tarafından sağlanan permabilite bariyerine bağlı olarak birçok antibiyotiğe doğal direnç gösterir. Biyofilm formunda yüzeyleri kolonize etme eğilimi, hücreleri terapötik dozlardan etkilenmez hale getirir. Gentamisin-Karbenisilin veya Tobramisin-Tikarsilin kombinasyonları kullanılabilir.
Gram boyama (P. aeruginosa)
P. aeruginosa kolonileri (floresan pigment-pyoverdin)
P. aeruginosa kolonileri (mavi pigment-pyocyanin-)
Hi. Fluoro Pseudomonas Agar’da Pseudomonas aeruginosa
Cetrimide Agar’da yeşil pigment
Mac. Conkey Agar’da P. aeruginosa
P. aeruginosa (flagella)
EM’bik görünüm (P. aeruginosa)
EM’bik görünüm (P. aeruginosa)